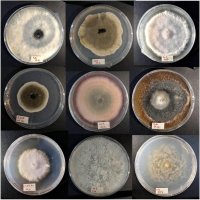

Guanajuato, Gto., a 09 de abril de 2025.- Profesoras investigadoras de los Departamentos de Biología e Ingeniería Geomática e Hidráulica de la Universidad de Guanajuato (UG), han unido su trabajo para identificar y analizar los hongos fitopatógenos que afectan a las emblemáticas cactáceas de la región.
Se trata de la Dra. Michelle Farfán Gutiérrez, del Departamento de Ingeniería Geomática e Hidráulica de la División de Ingenierías, la Dra. Ana Lilia Martínez Rocha y la Dra. Suria Gisela Vásquez Morales, del Departamento de Biología de la División de Ciencias Naturales y Exactas.
Las investigadoras publicaron recientemente —el 7 de abril— un trabajo de investigación al respecto, en la revista El Aullido de la Comisión Nacional de Áreas Naturales Protegidas (CONANP) del Gobierno de México.
El documento quedó publicado bajo el título “Marchitez en el desierto: El impacto de hongos fitopatógenos en las cactáceas guanajuatenses”, en donde alertan sobre la amenaza silenciosa que se cierne sobre los nopales, garambullos y agaves con síntomas de marchitamiento en el Cerro del Sombrero, dentro del Área Natural Protegida “La Purísima”.
Se expone que las cactáceas son símbolos icónicos del paisaje semiárido del estado de Guanajuato, hábitat de múltiples especies nativas, y están actualmente en riesgo: “Desde el año 2017, se han registrado altas temperaturas y una disminución de la precipitación trayendo consigo efectos negativos en la vegetación semiárida”.
Recuerdan que, según el Monitor de Sequía de la Comisión Nacional de Agua, el estado de Guanajuato ha presentado distintos niveles de sequía meteorológica, ubicándose en las categorías de anormalmente seco a sequía severa. “Por consiguiente, la vegetación nativa presenta una reducción de la fotosíntesis que desencadena lento crecimiento, estrés, marchitamiento, aumento de enfermedades y culmina en la muerte de la planta”.
Las universitarias, en los últimos meses, han monitoreado un aumento alarmante en la prevalencia de infecciones por hongos fitopatógenos en poblaciones de nopales, garambullos y agaves; consideran que la magnitud de esta infección es motivo de preocupación, debido a que afecta áreas extensas, particularmente en el municipio de Guanajuato, con indicios de estar presente en otras regiones del norte del estado.
“Esta problemática en la vegetación nativa amenaza con alterar los servicios ambientales que proveen en la región, desde ser un sumidero de carbono hasta proveer alimentación para la fauna y fuente económica para las poblaciones locales”.
Alertan que esta afectación se ha identificado de manera intensa en el Cerro del Sombrero, dentro del territorio que comprende el Área Natural Protegida Estatal Presa de la Purísima, en el municipio de Guanajuato, sitio donde se presenta una vegetación de selva baja caducifolia, compuesta por mezquite, casahuate, palo cuchara y matorral xerófilo, compuesto por nopal, joconostle, cardón, garambullo y agave. En esta zona, hay también una importante fauna, con patos, gansos, garzas y aguilillas, entre otras aves.
“Con el apoyo del Comité Estatal de Sanidad Vegetal de Guanajuato (CESAVEG), se realizó un análisis mediante caracterización morfológica de los microorganismos presentes en las muestras tomadas en el Cerro del Sombrero que reveló al hongo fitopatógeno Fusarium oxysporum como uno de los causantes del marchitamiento de cactáceas, como el nopal y el garambullo”, sostienen las investigadoras.
Explican que este hongo es conocido por causar marchitez vascular en diversas plantas de interés agrícola y forestal. Por tanto, representa una amenaza significativa para la salud y supervivencia de estas especies cruciales en el ecosistema. Destacan también que existe un reporte fitosanitario ante el Comité Estatal de Sanidad Forestal de la Promotoría de la Comisión Nacional Forestal (CONAFOR).
Ante esa situación, las académicas universitarias han iniciado una línea de investigación exhaustiva que incluye análisis morfológicos y moleculares para identificar y caracterizar todos los agentes patógenos involucrados. Hasta el momento, han aislado 36 cepas de hongos de las muestras obtenidas en el Cerro del Sombrero, los cuales se encuentran en fase de identificación morfológica. Además, se están estudiando los factores que favorecen su propagación, con el objetivo de desarrollar estrategias de manejo y control efectivas in situ.
“La crisis que enfrentan los ecosistemas en un contexto de calentamiento global resalta la importancia de la investigación científica en la búsqueda de soluciones a problemáticas ambientales emergentes”, destaca el artículo publicado.
Se pondera, en ese sentido, que “la investigación que se está llevando a cabo en la UG es un ejemplo palpable de cómo el análisis riguroso puede ofrecer luz ante desafíos ambientales complejos” y, sobre todo, que la protección del patrimonio natural exige una sinergia entre academicos, entidades gubernamentales y población afectada, para asegurar un futuro sostenible.
El artículo completo puede ser consultado en el siguiente enlace: www.elaullador.conanp.gob.mx/index.php/2025/04/07/marchitez-en-el-desierto-el-impacto-de-hongos-fitopatogenos-en-las-cactaceas-guanajuatenses/?fbclid=IwY2xjawJjjDRleHRuA2FlbQIxMAABHtthUgUAcn_4cA9iD5-WW9-Z94KZk97wy9lUD0Oe6xvnIcmg4T3isHbA_N-T_aem_9pzcdpk5ClUzrW1uDQfCJw